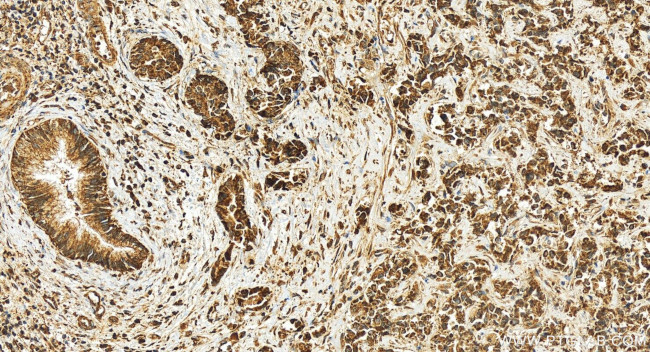
RCCD1 Antibody in Immunohistochemistry (Paraffin) (IHC (P))

Search
Proteintech
RCCD1 Polyclonal Antibody
{{$productOrderCtrl.translations['antibody.pdp.commerceCard.promotion.promotions']}}
{{$productOrderCtrl.translations['antibody.pdp.commerceCard.promotion.viewpromo']}}
{{$productOrderCtrl.translations['antibody.pdp.commerceCard.promotion.promocode']}}: {{promo.promoCode}} {{promo.promoTitle}} {{promo.promoDescription}}. {{$productOrderCtrl.translations['antibody.pdp.commerceCard.promotion.learnmore']}}
产品信息
24446-1-AP
种属反应
宿主/亚型
分类
类型
抗原
偶联物
形式
浓度
纯化类型
保存液
内含物
保存条件
运输条件
产品详细信息
Immunogen sequence: MAEERPGAWF GFGFCGFGQE LGSGRGRQVH SPSPLRAGVD ICRVSASWSY TAFVTRGGRL ELSGSASGAA GRCKDAWASE GLLAVLRAGP GPEALLQVWA AESALRGEPL WAQNVVPEAE GEDDPAGEAQ AGRLPLLPCA RAYVSPRAPF YRPLAPELRA RQLELGAEHA LLLDAAGQVF SWGGGRHGQL GHGTLEAELE PRLLEALQGL VMAEVAAGGW HSVCVSETGD IYIWGWNESG QLALPTRNLA EDGETVAREA TELNEDGSQV KRTGGAEDGA PAPFIAVQPF PALLDLPMGS DAVKASCGSR HTAVVTRTGE LYTWGWGKYG QLGHEDTTSL DRPRRVEYFV DKQLQVKAVT CGPWNTYVYA VEKGKS
靶标信息
Plays a role in transcriptional repression of satellite repeats, possibly by regulating H3K36 methylation levels in centromeric regions together with KDM8 (PubMed:24981860). Possibly together with KDM8, is involved in proper mitotic spindle organization and chromosome segregation (PubMed:24981860). Plays a role in regulating alpha-tubulin deacetylation and cytoskeletal microtubule stability, thereby promoting cell migration and TGF-beta-induced epithelial to mesenchymal transition (EMT), potentially through the inhibition of KDM8 (PubMed:28455245).
仅用于科研。不用于诊断过程。未经明确授权不得转售。
篇参考文献 (0)
生物信息学
蛋白别名: RCC1 domain-containing protein 1
基因别名: RCCD1
UniProt ID: (Human) A6NED2
Entrez Gene ID: (Human) 91433